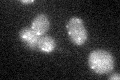
YDR265W
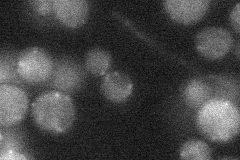
YDR265W
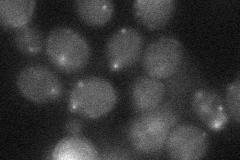
YDR265W
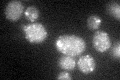
YDR265W
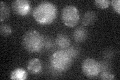
YDR265W

View description
Peroxisomal membrane E3 ubiquitin ligase required for for Ubc4p-dependent Pex5p ubiquitination and peroxisomal matrix protein import; contains zinc-binding RING domain; mutations in human homolog cause various peroxisomal disorders
Localization:
Intensity:
Fold change:
Significance:
-
C’ GFP library in SD
punctate17.14 -
N' NOP1pr-GFP in SD

punctate41.4593 -
N' TEF2pr-mCherry in SD

punctate25.1554 -
N' NATIVEpr-GFP in SD
below threshold21.0952 -
N' TEF2pr-VC and Cyto-VN in SD
below threshold26.101 -
C’ GFP library in SD+DTT
punctate16.610.96No -
C’ GFP library in SD+H2O2

punctate17.050.99No -
C’ GFP library in Starvation Media
punctate18.191.06No -
C’ GFP library on the background of Pup2-DaMP

N/A -
C’ GFP library on the background of CCT mutant

N/A0N/AYes
